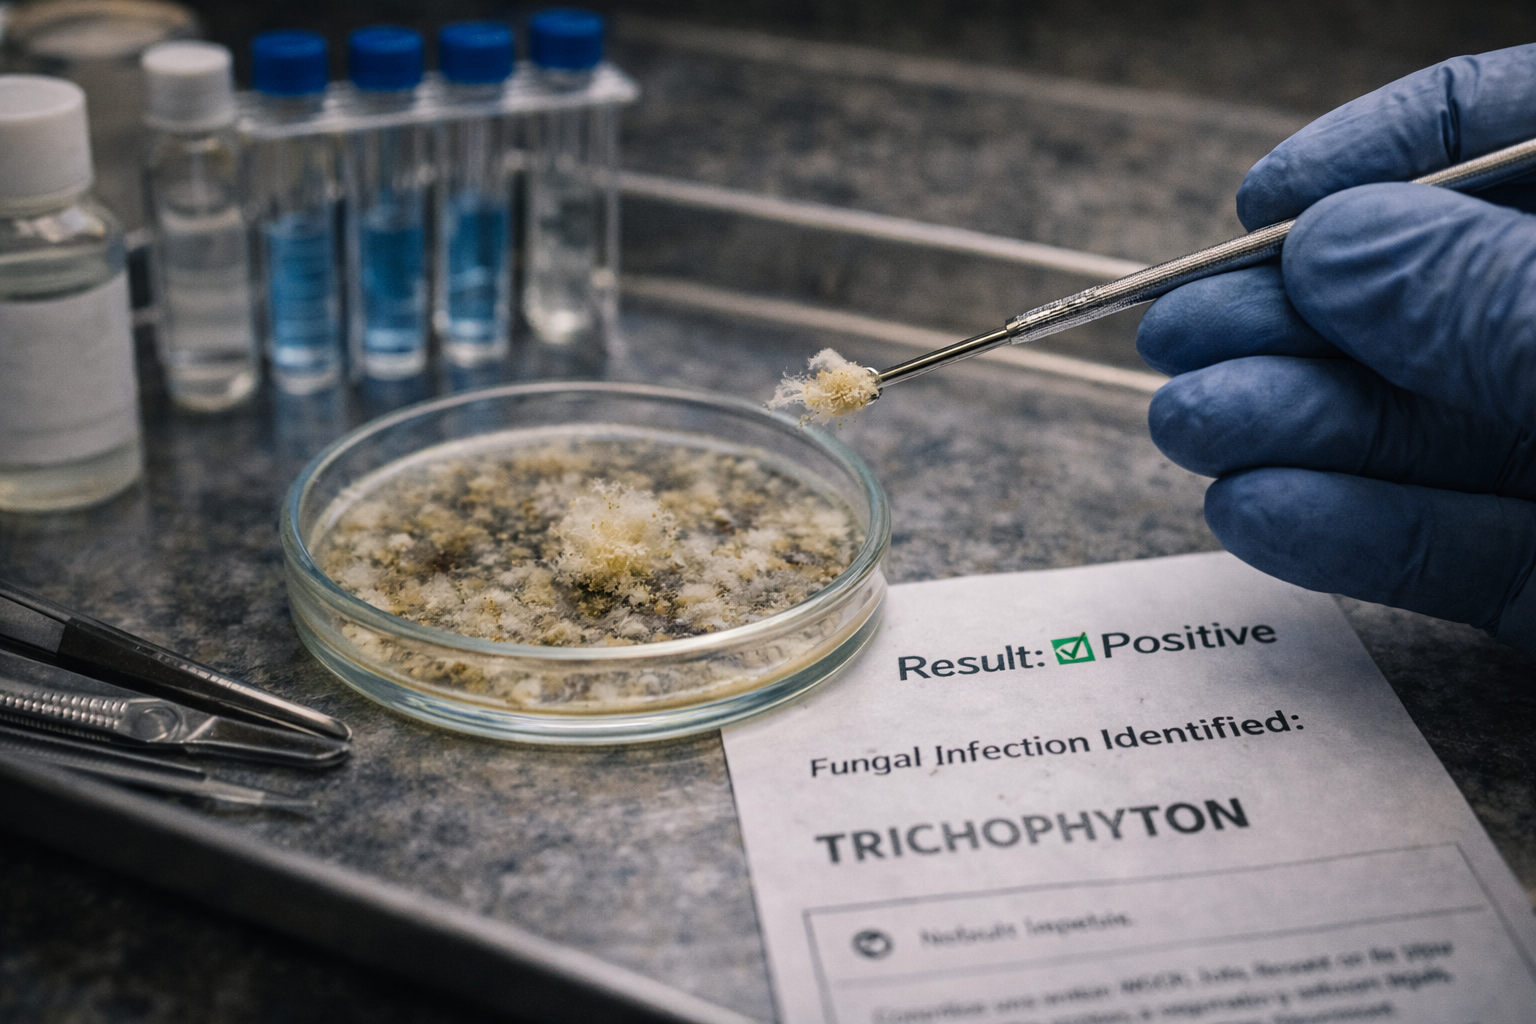
Accurate fungal nail sample being taken deep within the nail plate at General Foot Care Arnold

Fungal Nail
Test.
Get a definitive answer in minutes — not weeks. Our in-clinic fungal nail test is quick, completely pain-free, and 97% accurate. No waiting for GP lab results, no guessing, no wasted months on the wrong treatment.
The key difference? We trim the nail back and take the sample from deep within the nail plate — where the fungus is actually active. GP samples taken from the nail tip often pick up only surface debris, leading to false negatives. If your GP test came back negative but your nails are still discoloured, we can retest with a method proven to be far more sensitive.

Did You Know?
GP fungal nail tests can come back negative even when an infection is present. This often happens because the sample is taken from the tip of the nail, which may only contain surface debris — not the active fungus deeper in the nail plate. Our in-clinic test uses a more sensitive sampling technique and gives you results in minutes rather than weeks.
Do Any of These Sound Familiar?
Fungal nail infection can be difficult to identify without a proper test. Here are the most common signs that testing is recommended — including situations where a previous GP test may have missed the infection.
Discoloured Nails
Yellow, brown, white, or greenish nails are one of the first and most obvious signs of a fungal infection — especially if the change has been gradual.
Thickened or Brittle Nails
If your nail has become noticeably thicker, crumbly, or difficult to cut, a fungal infection is likely causing structural damage within the nail plate.
Nail Lifting or Separation
Fungal infections can cause the nail to separate from the nail bed (onycholysis), leaving a gap beneath the nail that can harbour further infection.
Buildup Under the Nail
A powdery or chalky buildup of debris under the nail is a classic indicator that fungi are active deeper within the nail plate — exactly where our sample is taken from.
GP Test Was Negative
GP results can come back negative even when a fungal infection is present — often because the sample was taken from the wrong part of the nail. We retest using a more sensitive and accurate method.
Spreading to Other Nails
Fungal nail infections are contagious and can spread to other toenails, fingernails, and the skin. Early and accurate testing means early treatment and less spread.
How We Test — And Why It Matters
The accuracy of a fungal nail test depends almost entirely on where the sample is taken from. Our technique targets the most active part of the infection for a result you can trust.
Nail Examination
Your podiatrist examines the affected nail under magnification, assessing the pattern of discolouration, thickness, and nail bed involvement to identify the most active area.
Nail Preparation
We carefully trim the nail back to expose the nail plate where the fungal infection is most concentrated — not just the surface tip or debris, which can give false negatives.
Sample Collection
A sterile instrument is used to collect a sample from deep within the nail plate. This is the key difference between our method and a standard GP referral — the sample location matters enormously.
In-Clinic Testing
The sample is tested in-clinic using our dermatophyte detection method, giving you a clear, reliable result within minutes. If positive, we can discuss the right fungal nail treatment straight away.
Why Our Test Beats
the GP Method
- 97% accurate — significantly more sensitive than GP lab methods
- Results within minutes, not weeks
- We trim the nail back and sample from deep within the nail plate, where the fungus is most active
- We retest patients whose GP result was negative but nails remain symptomatic
- Avoids wasted months on the wrong antifungal treatment
- Identifies the specific type of fungal infection for targeted treatment
- Performed in-clinic by an experienced Arnold podiatrist
- Completely pain-free — no injections or discomfort involved
What to Expect at
Your Test Appointment
Arrive With Clean, Polish-Free Nails
Please remove any nail varnish, gel, or polish from the affected nail before your appointment to allow accurate visual and sample assessment.
Visual Assessment
Your podiatrist examines the nail under magnification, assessing colour, thickness, separation, and debris to identify the best sampling site.
Sample Taken from Deep Within the Nail
We trim the nail back and take the sample from the nail plate where the fungus is most active — not the surface tip. This is the critical step that makes our test more reliable than a GP referral.
Results & Next Steps
You receive your result in minutes. If positive, we discuss the most appropriate treatment plan immediately. If negative, your podiatrist investigates other possible causes.
97%
Accuracy Rate
Minutes
For Results
0
Pain or Injections
Important Pricing Note
The fungal nail test is not included in the price of a standard fungal nail treatment appointment. It is an additional service charged separately. Your podiatrist will confirm the cost before proceeding. We recommend testing to all new patients presenting with nail discolouration to ensure the correct treatment from the very first appointment.
Already Had a Negative GP Test?
Do not assume your nails are clear if they still look discoloured. A negative GP result does not always mean no infection. Our more sensitive method — which samples from deeper within the nail — can identify infections that standard GP tests miss. Book a retest with us for complete peace of mind.
Book a RetestServing patients across Nottinghamshire
FAQs
Fungal Nail Test FAQs
A fungal nail test confirms whether a fungal infection (onychomycosis) is present in your nail. Accurate testing is essential because other conditions — such as psoriasis, trauma, or nail thickening — can look identical to fungal nail. Without a confirmed diagnosis, you could spend months on the wrong treatment. Our 97% accurate in-clinic test gives you clarity in minutes.
Standard GP nail samples are often taken from the tip of the nail or superficial nail debris. If the fungus is active deeper within the nail plate, these samples can come back falsely negative. At General Foot Care, we trim the nail back properly and collect the sample from deep within the nail plate — where the fungus is most active. This technique gives a much higher detection rate.
Yes. This is a common situation we see regularly. GP results can vary significantly depending on the person who took the sample and which part of the nail it was taken from. A sample from the very nail tip may only contain surface debris and not the active fungus. We can retest you using our more sensitive in-clinic method and give you a reliable result the same day.
Not at all. The test is completely pain-free. We trim the nail back and take the sample using a sterile instrument — there are no injections or invasive procedures involved. The whole process takes just a few minutes.
Results are available within minutes of the sample being taken. Unlike a GP lab referral — which can take 2 to 6 weeks — our in-clinic testing means you leave knowing whether fungal nail infection is present and can start the right treatment immediately if needed.
No — the fungal nail test is an additional service and is not included in the standard fungal nail treatment appointment price. Your podiatrist will explain the cost clearly before proceeding. Many patients consider it essential to ensure they are on the correct treatment from day one.
If the test confirms a fungal nail infection, your podiatrist will recommend the most appropriate treatment straight away — whether that is a topical antifungal, a course of oral medication in conjunction with your GP, or our specialist nail treatment. Starting the right treatment early leads to significantly better outcomes.
A negative result means no active fungal infection was detected. Your podiatrist will then assess whether another condition — such as nail trauma, psoriasis, or nail thickening from pressure — may be causing the discolouration, and advise on the appropriate next steps.
Yes. You can book a standalone fungal nail test appointment to confirm or rule out infection before committing to a treatment plan. This is a popular option for patients who want clarity before deciding how to proceed.
Please remove any nail varnish, gel nails, or nail polish from the affected nail before your appointment, as this can interfere with visual assessment and sample collection. Arrive with clean, dry feet for the most accurate result.
Our fungal nail testing service is based at General Foot Care in Arnold, Nottingham. We serve patients across Nottinghamshire including Sherwood, Mapperley, Hucknall, Carlton, Gedling, West Bridgford, Bestwood, Daybrook, and surrounding areas.
Yes. Fungal nail infections are contagious and will spread to other toenails, fingernails, and the surrounding skin if left untreated. They can also be passed to other people in the household. Early testing and early treatment is the most effective way to prevent spread and achieve full nail restoration.
Get a Definitive Answer Today
Stop guessing and stop wasting months on the wrong treatment. Our 97% accurate in-clinic fungal nail test gives you results in minutes — and we can start the right treatment immediately.